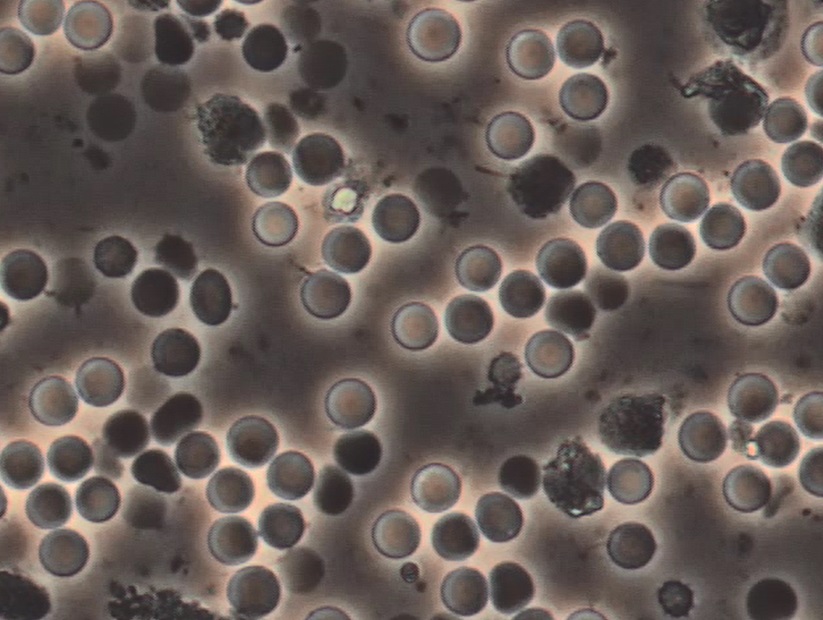
赤血球

皆様寒くなりましたね。最近風邪のため患者さんのキャンセルが急増しています。体調管理にはお気を付けください。私も先日インフルエンザの予防接種に行ってきました。
さて、歯周内科のご紹介の続きです。
当院で歯周内科を導入しまして、続々と良好な結果を出しております。後でご紹介しましょう。
それでは、口腔内で顕微鏡で観察されるさまざまな菌について性質や特徴について解説いたしましょう。
①トレポネーマ

こちらはらせん状の菌で、顕微鏡で容易に観察されやすい歯周病菌なので一番わかりやすく、この菌がいっぱいいて元気に活動しているようなら歯周内科を行う有力な指標となります。
- グラム陰性で嫌気性
- 大型、運動性、らせん状菌
- スピロヘータ属
- 免疫反応を制御して炎症の慢性化に関与
- 難治性の歯周病患者で歯茎から排膿しているところに必ず存在している
- 歯周内科では除菌されやすい菌
- 人の腸管や泌尿・生殖器表面からも検出される
②運動性桿菌

- 棒状の菌で菌種は特定できませんが歯周病が進行しているところに密集して観察されます
③カンジダ

- 真菌
- 動かない
- 大きくなる。形を変える
- 球菌と相性が良く共生して集まる
④アメーバ

- 直径が10~30ミクロンの大きさ
- アメーバ状の動きをする
- 白血球や最近を貪食する
⑤トリコモナス

- 10ミクロン程度の大きさ
- 歯周病が進行した患者の口腔内に観察される
- 接触感染する
⑥生体由来細胞

滑落上皮・赤血球・白血球・リンパ球
主に以上の種類の菌や微生物、細胞が位相差顕微鏡で観察されます。
菌については位相差顕微鏡で確定できるものはありません。
位相差顕微鏡で判断できるものは菌の形態や運動性、量となります。
その顕微鏡像により正常菌叢、悪い菌叢、非常に悪い菌叢の判定が可能です。
顕微鏡像で悪い菌層が疑われたら、菌を確定するために更なる細菌検査としてリアルタイムPCR検査が必要となります。
PCR検査について簡単に説明するとPCR検査とは固有の遺伝子(DNA)を増幅させて調べます。患者さんの歯周ポケットよりプラークを採取して生田図南先生が運営している熊本天草にあるMICROEXAM社に検体を送りそこにある検査設備にて正確に菌の種類と量を調べていきます。
そこで調べることが可能な菌は全部で6種類あります。
それぞれ特徴を解説していきましょう。
① Treponema denticola(トレポネーマ デンティコーラ)=T.d菌
顕微鏡で観察できる菌として前述して解説しておりますので説明は省きます
② Porphyromonas gingivalis(ポルフィロモナス ジンジバリス)=P.g菌
- タンパク分解酵素があり、歯周病の発症と進行の原因になっている
- 進行した歯周炎の病巣から検出される
- グラム陰性、嫌気性、非運動性短桿菌
- 黒色色素産生する
- 赤血球共凝集因子
- 内毒素で歯槽骨を吸収する
- 硫化水素の悪臭を放つ
- アテローム性動脈硬化症や糖尿病や早産の原因となる
- タイプが6種類あり、タイプⅡと呼ばれている種類は特に凶暴
この菌が一番悪いとみなされています。黒色色素の産生と赤血球とくっつくことで歯肉が赤黒くなります。PCR検査でP.g菌のタイプⅡを独自に検出することも出来ます。
③ Tannerella forsythia(タンネレラ フォーサイシア)=T.f菌
- グラム陰性、嫌気性
- 非運動性桿菌
- 歯周病の進行期、活動部位に多い
- P.g菌とともに存在すると歯周炎は悪化する
- 難治性歯周炎の指標となる重要な菌種である
- 歯周内科治療において、比較的除菌しにくい菌
④ Aggregatibacter actinomycetemcomitans
(アグリゲイティバクター アクチノミセテムコミタンス)=A.a菌
とても長い名前ですね。
- グラム陰性、嫌気性
- 非運動性短桿菌
- 侵襲性歯周炎、慢性歯周炎の原因菌
- 白血球毒素、細胞膨張化毒素を持つ
- 内毒素(LPS)により歯槽骨を吸収する
- 免疫応答を抑制する
若年性歯周炎や侵襲性歯周炎など特殊な歯周炎の原因菌として考えられています。しかし、菌が存在しても問題がない場合があり、宿主(感染者)の反応によって病原性が異なるようです
⑤ Prevotella intermedia(プレポテラ インターメディア)P.i菌
- 嫌気性グラム陰性桿菌
- 女性ホルモンにより発育が促進されるため、妊娠性歯肉炎、月経周期関連歯肉炎、思春期性歯肉炎で多く見られる
- 黒色色素を産生する
⑥ Fusobacterium nucleatum(フソバクテリウム ヌクレアタム)=F.n菌
- 紡錘状で非運動性の細長い桿菌
- グラム陰性、嫌気性
- 20µm~100µmの大きさで、菌としては非常に大きく、紡錘菌とも言われる
- ギ酸、乳酸、酪酸を産生する
- 悪臭を伴う
- 赤血球と結びつく
- デンタルバイオフィルム形成に中心的役割を担う
- 歯周内科治療において比較的常勤しにくい菌
さらに最近では大腸がんに関係しているのではという報告もあります
以上これら6種の菌の存在をPCR検査で数値として確認することができます。
それではPCR検査について詳しく説明しましょう。
検査はとっても簡単です。
痛くはありません。
口腔内の一番歯周病の進行している歯の周りの歯周ポケットの中にペーパーポイントという紙製のポイントを4か所挿入して30秒ほど待ってから取り出し一晩乾燥させます。
それを検体としてMICROEXAM社に郵送して1週間から10日ほどすると検査結果が送られてきます。
それがこの報告書です。

検査項目として検出されたすべての菌の総菌数、6種類の歯周病菌のそれぞれの測定値、単位(Copies)、基準値(菌それぞれで1、000以下、RED COMPLEXとして3、000以下、A.a菌のみ0)、対総菌数比率、単位(%)、比率クラス(0-4)
としてそれぞれの測定値、判定が表示されてきます。
この方の報告書のデータを順番にみていきましょう。
①は総菌数で、検体から検出された菌の総数となっています。この方は総菌数が500万近くで、採取した場所に左右されますが、かなり多くの細菌がいると判断されます
②はP.g菌の測定値、③はT.d菌の測定値、④はT.f菌の測定値、⑤はこれら3つの菌の総称RED COMPLEXとしての合計でそれぞれ約120万、約80万、約30万、約230万となっています。基準値はそれぞれ1000以下、1000以下、1000以下、3000以下なのでいずれも大きく上回っていました。
報告書にはRED COMPLEXの判定基準の評価が載っています。

0~3000以下は良好、3001~10000は注意、10001以上は要相談・要治療という評価となります。
また、それぞれ菌がたくさん検出されましたが、総菌数も多いので重要なのは総菌数に対する割合がどれくらいかということです。
⑩、⑪、⑫がP.g菌、T.d菌、T.f菌の対総菌数比率でそれぞれ25%、16%、6%で⑬のRED COMPLEXとしては47%も占めていて約半数が悪性の歯周病菌となっており、口腔内の細菌の状態が極めて悪い菌叢になっていることがわかります。
対総菌
数比率を受けて、比率クラスが判定されます。

0~4の5段階となっており0の良好から4の注意に分けられ評価されます。
この患者さんの判定は対総菌数比率が非常に高かったのですべて最高値の4となっておりました。歯周内科では比率クラスを下げることが目標となります。
⑦のA.a菌は1個でも検出されると異常値となり、治療必要と判定されますが、このケースでは0で検出されませんでした。

⑨のF.n菌は対総菌比率は対象外ですが、基準値の1000を上回る約9万個検出されたのでこちらも非常に多くなっています。RED COMPLEXの温床となり、大腸がんの原因にも考えられているので、除菌しにくい菌ですが歯周内科で減らしていきたいところです。
⑥のP.g菌TypeⅡ、⑧のP.i菌はオプションとなります。通常P.g、T.d,T.f,A.a,F.n菌の5菌種を測定します。最低でもRED COMPLEXの3菌種を測定いたします。
それではある患者の歯周内科前と歯周内科後のPCR検査の報告書をお見せします。


2か月程でこんなに改善しました!


